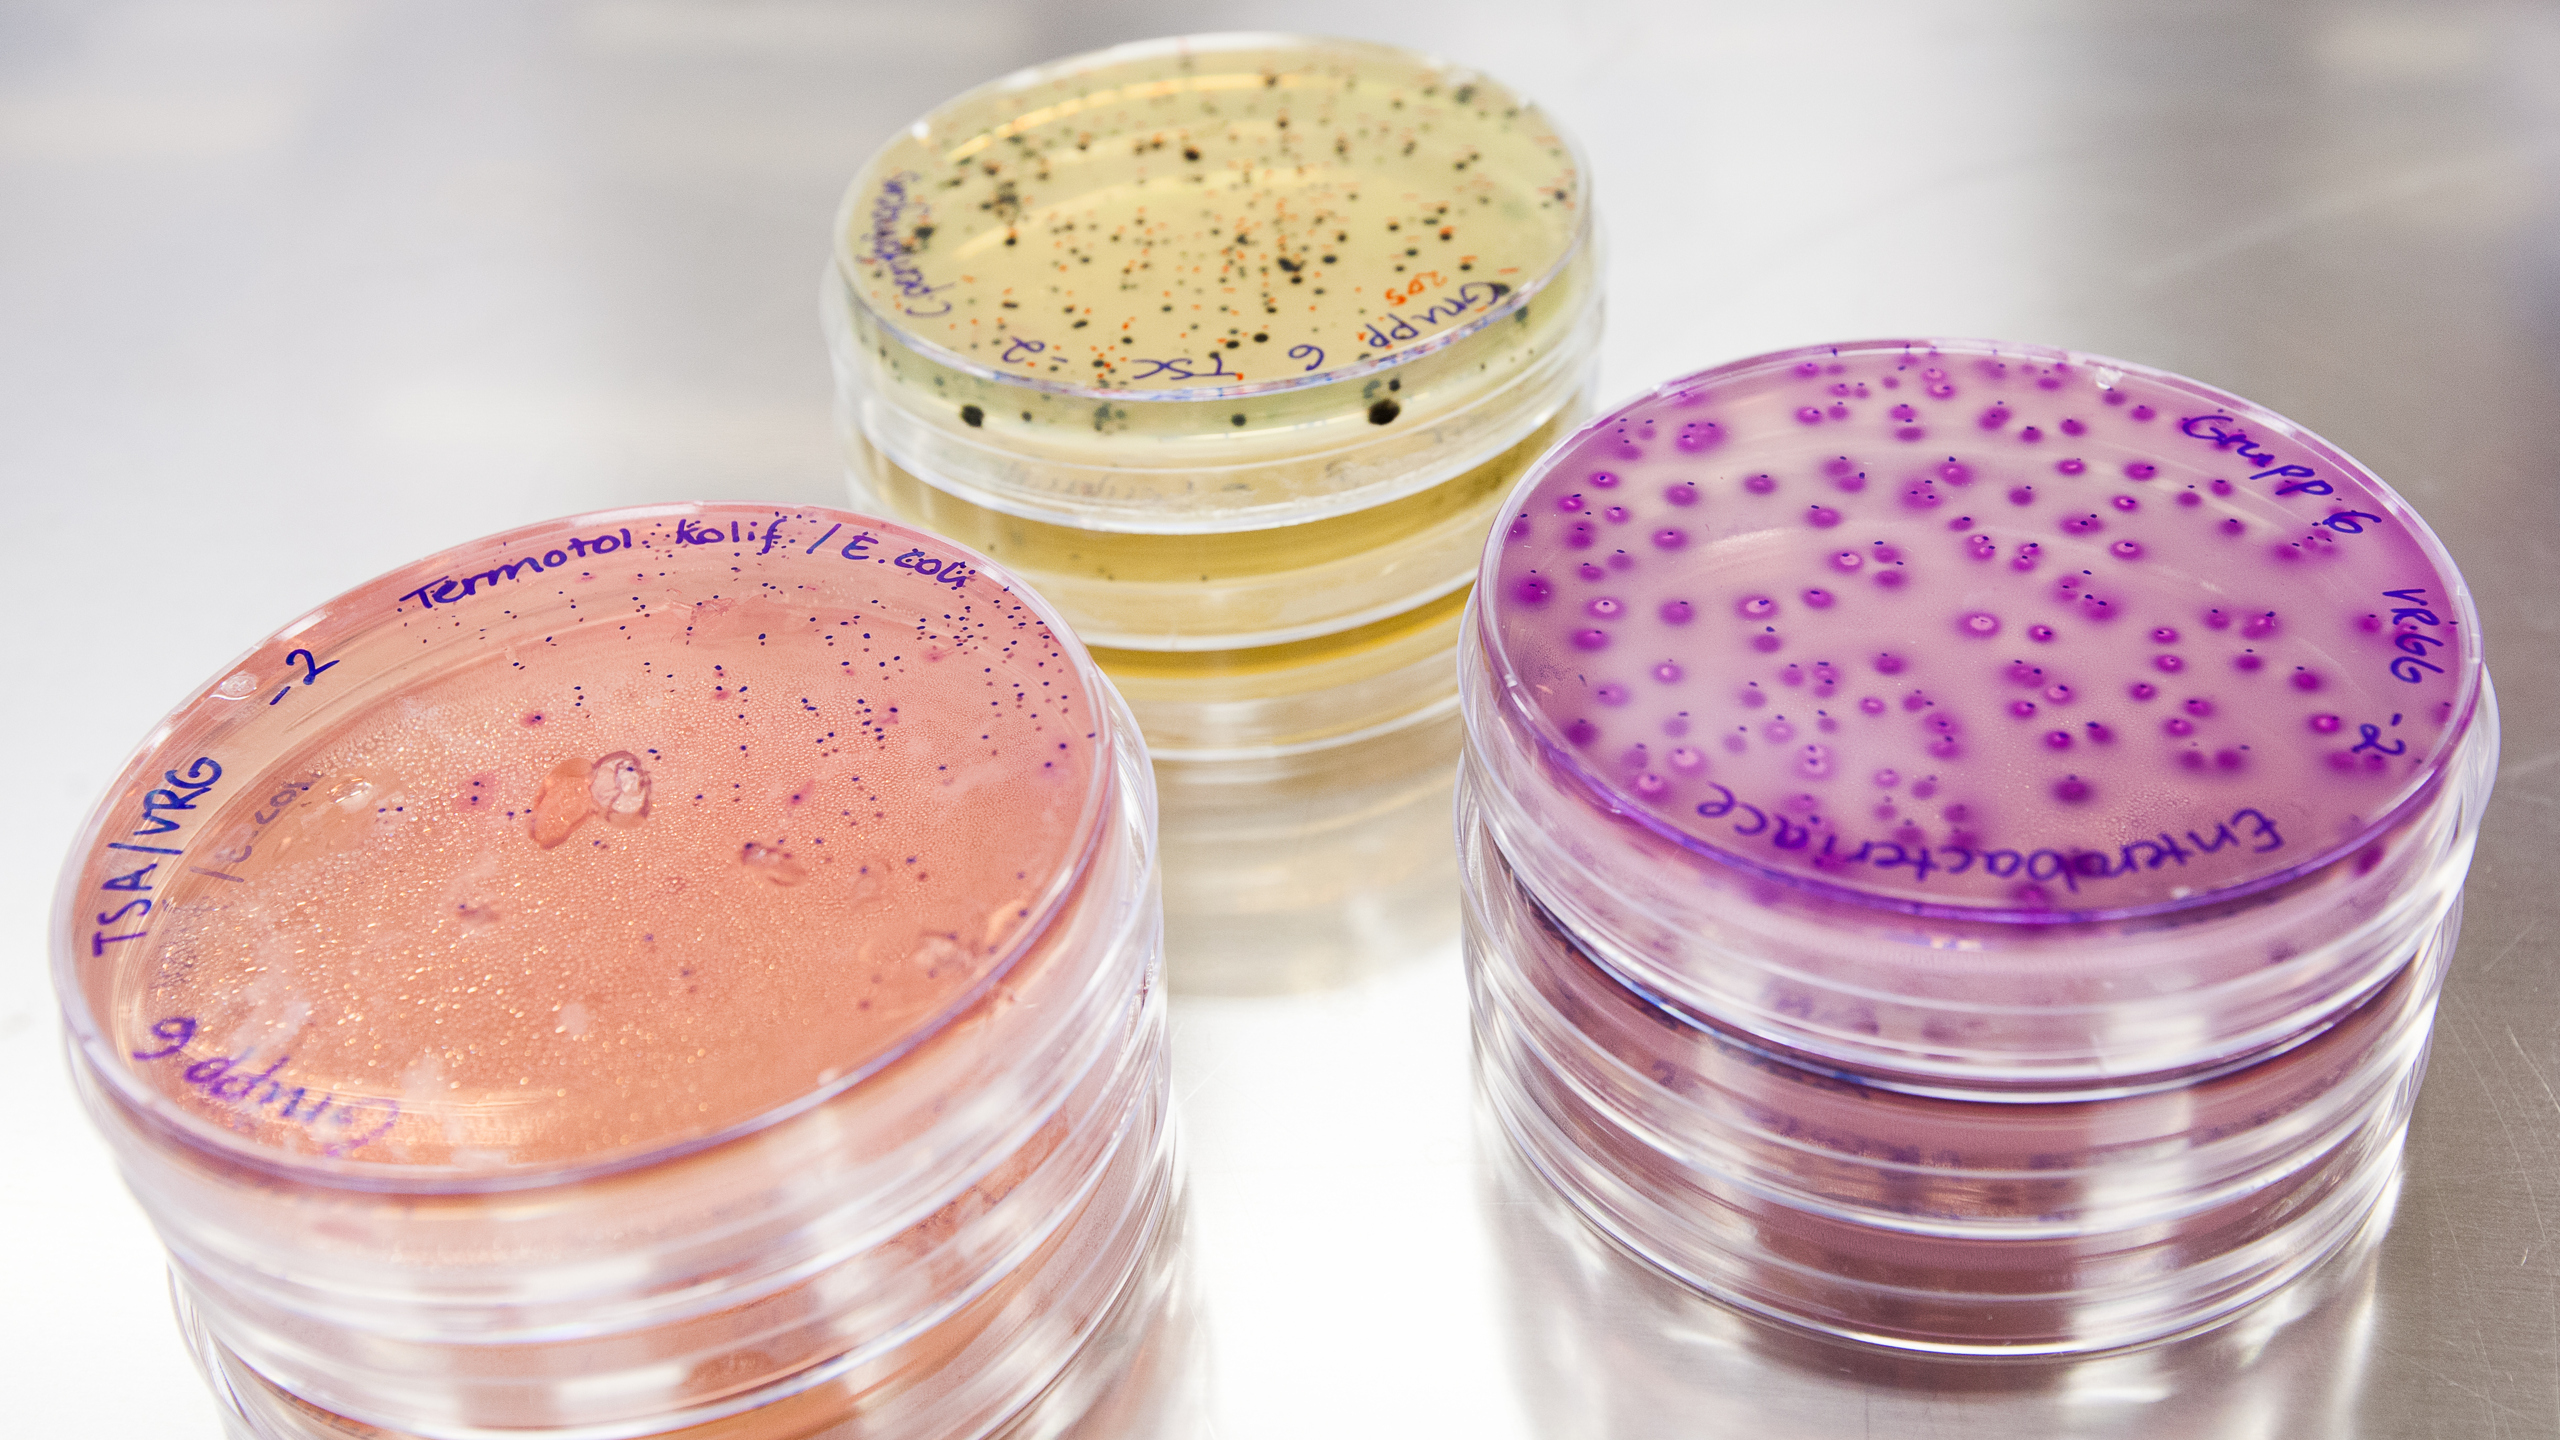
Bakterieodlingar i petriskålar. Foto.

Livsmedelssäkerhet 30 år efter Sverige gick med i EU
När Sverige blev EU-medlem flyttade besluten om livsmedelssäkerhet till Bryssel. Resultatet blev kompromisser, men också nya möjligheter till påverkan.
Text: Ivar Vågsholm, professor vid Institutionen för husdjurens biovetenskaper
Vid tiden för Sveriges EU-inträde skilde sig den svenska livsmedelsproduktionen från många andra EU-länders på flera områden som rörde livsmedelssäkerhet och djurskydd. Särskilt framhävdes en långtgående salmonellakontroll, kadaverförbud, förbud mot användning av antibiotika i tillväxtbefrämjande syfte samt särskilda krav på djurvälfärd, såsom beteskrav för mjölkkor och minimikrav på yta för slaktkycklingar.
EU-inträdet 1995 innebar stora förändringar i hur arbetet med livsmedelssäkerhet organiserades, men inte lika stora förändringar i den faktiska livsmedelssäkerheten. Trettio år senare har Sverige blivit mer likt EU, samtidigt som EU i flera avseenden också har blivit mer likt Sverige.
Den svenska modellen före EU
Före EU-inträdet var livsmedelssäkerhet främst en nationell angelägenhet. Kontrollen i primärproduktionen sköttes av Jordbruksverket, livsmedelskontrollen av kommunerna och kontrollen av slakterier av Livsmedelsverket. Arbetet hade ett starkt fokus på salmonella, mot bakgrund av erfarenheterna från Alvestaepidemin på 1950-talet.
Den svenska modellen kännetecknades av ingripande kontrollåtgärder i primärproduktionen. Vid konstaterad smitta slaktades hela besättningar, och djurstallar samt foderutrymmen rengjordes och desinficerades för att förhindra att salmonella spreds vidare i livsmedelskedjan. Fall av salmonella orsakade av svenska livsmedel var sällsynta.
Sverige hade även ett kadaverförbud, vilket innebar att självdöda djur inte fick användas som foder till andra djur, samt ett förbud mot antibiotika i tillväxtbefrämjande syfte. Ett annat viktigt inslag som bidrog till god djurhälsa och djurvälfärd var beteskravet för mjölkkor.
Samtidigt fanns kritik från folkhälso- och smittskyddshåll mot den svenska modellen. Kritiken handlade om att livsmedelskontrollen inte i tillräcklig grad prioriterade de största folkhälsoproblemen. Campylobacter var den vanligaste livsmedelsburna smittan i Sverige under åren före EU-inträdet. Till skillnad från salmonellakontrollen låg fokus här främst på råd till konsumenterna om kökshygien, till exempel att inte använda samma knivar och skärbrädor för rå kyckling och annan mat. Näringen fick i stor utsträckning själv ta ansvar genom ekonomiska styrmedel. Kycklinguppfödare som levererade campylobacterfri kyckling fick bättre betalt, vilket skapade incitament för förebyggande arbete.
Skulle EU-inträdet försämra läget i Sverige?
Inför EU-inträdet fanns en utbredd oro för att Sveriges goda djurhälsoläge och tillgång till säkra livsmedel skulle komma att försämras.
En av de största förändringarna i samband med EU-inträdet var att nästan all lagstiftning inom livsmedelsområdet blev EU-gemensam. Lobbyverksamhet och påverkansarbete flyttades i stor utsträckning från Stockholm till Bryssel. Förändringar i regelverk beslutas numera inom ramen för EU:s samrådsförfaranden mellan kommissionen och medlemsländerna.
Sverige fick behålla sina nationella krav på djurhållning utöver EU:s minimikrav. En konsekvens blev att andra medlemsländer kunde producera livsmedel med mindre restriktioner och exportera dessa till Sverige. När köttkonsumtionen ökade efter EU-inträdet skedde ökningen till stor del genom importerat kött. Under vissa perioder sjönk marknadsandelen för svenskt nötkött och slaktkyckling till omkring 50 procent. Detta upplevdes som en orättvisa av svenska lantbrukare och inom livsmedelsindustrin. Svenska mervärden gav inte alltid utslag i konsumenternas betalningsvilja, vilket i sin tur minskade incitamenten att investera i livsmedelssäkerhet som ett enbart nationellt projekt. Livsmedelssäkerhet kom därmed i allt högre grad att ses som en EU-fråga.
En viktig framgång för Sverige var att EU, baserat på en svensk rapport om antibiotika i foder från 1997, förbjöd användning av antibiotika i tillväxtbefrämjande syfte. Rapporten visade att antibiotikan visserligen gav vissa produktionsvinster, men att dessa inte stod i proportion till riskerna. Detta blev ett tydligt exempel på hur Sverige kunde påverka EU:s djur- och livsmedelslagstiftning genom vetenskapligt väl underbyggda argument.
Utbrotten av galna ko-sjukan (BSE), och insikten 1996 om att sjukdomen kunde överföras till människa, ledde till att EU införde betydligt striktare regler för kadaverhantering, slaktavfall och animaliska biprodukter. Förbudet mot kött- och benmjöl i foder är ett tydligt exempel. BSE illustrerar hur ett cirkulärt och i grunden mer resurseffektivt livsmedelssystem också kan innebära risker, genom att näringsflöden samtidigt blir smittvägar. Detta är en viktig lärdom i utformningen av framtida cirkulära livsmedelssystem.
Hur är det nu?
Efter 30 år i EU har både Sverige och EU förändrats. I flera fall har Sverige nått framgång genom att ta fram vetenskapliga underlag som stärkt den svenska ståndpunkten. I andra fall har händelser i omvärlden lett till skärpningar även av svenska regler. BSE-krisen resulterade exempelvis i att EU i dag har en striktare policy för kadaver och kött- och benmjöl än vad som var Sveriges linje före inträdet.
Under perioden efter EU-inträdet har svenskt lantbruk genomgått en omfattande strukturomvandling. Djurbesättningarna har blivit färre men större. Samtidigt finns många djurägare som inte identifierar sig som traditionella bönder. Det kan försvåra informationsspridning, särskilt till småskaliga producenter och de som producerar för husbehov.
I dag är mellan en tredjedel och hälften av de livsmedel som konsumeras i Sverige importerade. Det innebär att livsmedelsindustrin i högre grad måste hantera råvaror och produkter där sannolikheten för mikrobiologisk kontaminering kan vara större.
Salmonellakontrollen har blivit en tydligt EU-gemensam fråga. Reglerna har skärpts, särskilt inom fjäderfäuppfödning och äggproduktion. Länder med hög förekomst av salmonella måste vidta åtgärder som vaccination av föräldradjur. Resultatet har blivit en kraftig minskning av rapporterade salmonellafall, både inom EU och i Sverige, särskilt för fall smittade utomlands. Samtidigt har gamla smittämnen dykt upp i nya livsmedel, till exempel salmonella i sallad, och nya smittämnen som EHEC (enterohemorragisk *Escherichia coli*), som kan orsaka blodig diarré, har identifierats.
Campylobacter, ofta kopplat till kontaminerad slaktkyckling eller dricksvatten, är fortfarande lika vanligt som före EU-inträdet och utgör alltjämt det största hotet mot livsmedelssäkerheten i Sverige och EU. Det nya är att EU 2017 införde gemensamma mikrobiologiska kriterier vid slakt av kyckling.
Vad behövs i framtiden?
Den stora utmaningen under kommande år är att utveckla hållbara livsmedelssystem som kan säkerställa tillgången till näringsrika, välsmakande och säkra livsmedel, inom de ramar som sätts av klimat, resurstillgång och ekosystemens gränser.
Det kommer att kräva både animaliska livsmedelskedjor, växtbaserade system för spannmål och andra grödor samt marina livsmedelskedjor för fiske och akvakultur. Därutöver tillkommer sannolikt nya livsmedelssystem baserade på insektsodling, bättre utnyttjande av sidoströmmar, cellodlat kött och växtbaserade köttsubstitut. Samtliga dessa system innebär nya utmaningar för både hållbarhet och livsmedelssäkerhet, vilket gör en kunskapsbaserad hantering av målkonflikter nödvändig.
Under de senaste åren har omvälvande händelser i omvärlden gjort att livsmedelsberedskap och tillgången till insatsvaror fått ökad uppmärksamhet. En viktig insikt är att livsmedelssäkerhet och livsmedelstrygghet är två sidor av samma mynt, när vi skall hantera målkonflikter. Typiska frågor är: Betyder bäst före-datum att det finns risk för gifter efter utgångsdatum? Kan vi reducera matsvinnet kan fler få mat för dagen utan att resursåtgången för livsmedelsproduktion ökar, men måste vi då acceptera mindre säkra livsmedel? Inom EU är svaret att matsvinnet ska reduceras, och livsmedelssäkerheten behållas.
För livsmedels- och djurfrågor behövs en kunskapsbaserad avvägning och hantering av målkonflikter. Samarbeten mellan nordiska och baltiska länder samt inom EU ger oss en djupare kunskapsbas för en hållbar framtid. Här har SLU en viktig roll att bidra till en kunskapsbaserad övergång till en mer hållbar, robust och säker livsmedelskedja från jord till bord i en otrygg och komplex omvärld.
Sverige, EU och maten
År 2025 är det 30 år sedan Sverige gick med i EU. Vad har det betytt för svenskt lantbruk, fiske och matkultur? I en rad olika artiklar från våra forskare belyser vi olika aspekter av hur EU-medlemskapet har påverkat och omformat det svenska livsmedelssystemet.